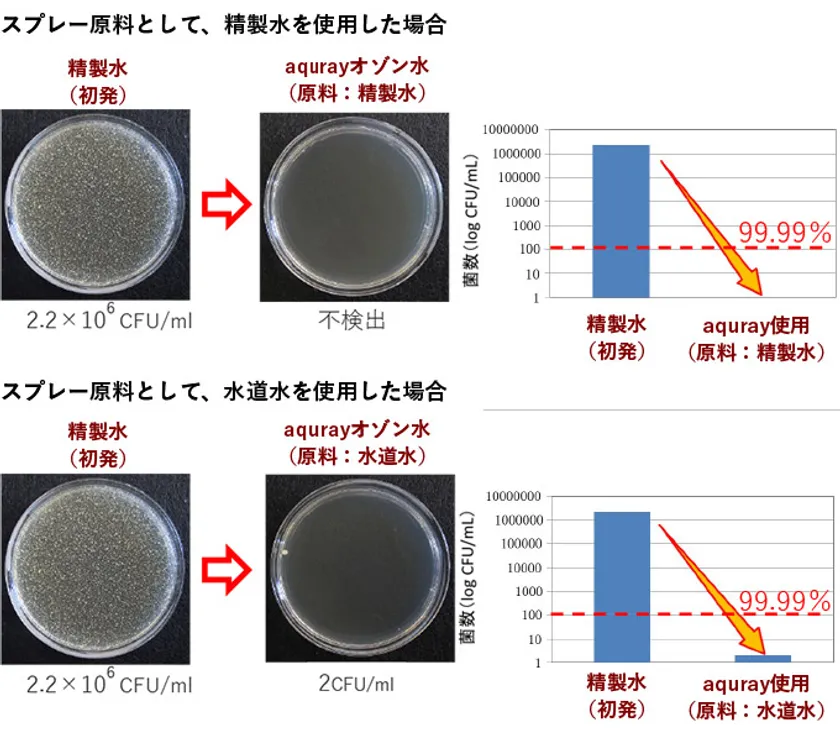

オゾン水濃度業界最高水準、水だけで簡単に除菌できる ハンディータイプオゾン水生成スプレーaquray(アクレイ)が 水道水や市販の精製水なども選択可能に!
伯東株式会社(東京都新宿区、代表取締役社長:阿部 良二)は、近年発生のウイルスや菌に対する危機管理のニーズが高まる中、2020年5月より水だけで安全かつ手軽に除菌・消臭できるオゾン水を生成できるハンディータイプオゾン水生成スプレーaquray(アクレイ)を企業・施設向けに販売開始しております。
この度、お客様のニーズに合わせた使用方法を実現するために、スプレーの原料として使用する水の種類を拡大すべく実証試験を重ねた結果、原料として使用する水をaquray専用精製水だけでなく、お客様からご要望が多かった水道水、ミネラルウォーター、市販の精製水などご希望のタイプの水からも選択できる仕様になりましたので、お知らせいたします。

Ozone Water Spray “aquray” オゾン水生成スプレーaquray(アクレイ)
■オゾン水生成スプレーaquray(アクレイ)仕様の変更点
原料として使用できる水は、不純物が少なくオゾン水濃度を高く保てる「aquray専用高純度精製水」のみを使用可能としていましたが、お客様から多くのご要望をいただき実証試験を重ねた結果、使用できる水の種類を拡大することができ、オゾン水生成器業界では初めて、使用環境やニーズに合わせお客様が選択できる仕様に改訂しました。
具体的には、aquray専用高純度精製水のほかに、ドラッグストアなどで販売されている日本薬局方精製水をはじめとした精製水、水道水、ペットボトル飲料水(ミネラルウォーター)など、コストを抑えて手軽に使えるタイプの水も、原料として選べるようになりました。
各タイプの水のオゾン水濃度は表1の通りで、「aquray専用高純度精製水」使用時のオゾン濃度代表値が一番高く、水温25℃で2~3mg、水温5℃で最大7mg/L(業界最高水準)ではあるものの、ほかのタイプの水を使用した際も十分な除菌効果を得られる濃度となっています。
(原則として、異なるタイプの水は同時に併用できません。添付資料の「使用できる水 一覧表」もご覧ください。)

オゾン水生成スプレーaquray(アクレイ)の原料として使用できる水の種類
表1:使用できる水の種類とオゾン水濃度代表値(業界最高水準)

オゾン水生成スプレーaquray(アクレイ)使用できる水の種類とオゾン水濃度代表値
注:オゾン水濃度代表値はaquray 直線噴霧時のデータです。霧状噴霧の場合、直線噴霧と比較して30~50%程度オゾン水濃度が低下することがあります。また、オゾン水濃度は、使用する水の水質や環境(温度など)により変化します。
■オゾン水生成スプレーaquray(アクレイ)の特長
1. 水だけで簡単にオゾン水を生成可能
→aquray専用高純度精製水のほか、市販の日本薬局方精製水をはじめとした精製水、水道水、ミネラルウォーターなど、お客様の使用環境やニーズに合わせて原料水を選べるようになりました
2. コンパクトサイズでコードレス。どこでも手軽にオゾン水スプレー可能
3. オゾン水はウイルスや菌などと反応して水に戻るため、オゾン残留性ゼロ
4. 手荒れするリスクも極めて低く、肌にやさしい
5. 必要量だけオゾン生成するため、余剰なオゾンガス発生が少なく安全。
6. 安全設計(誤噴射防止機能、圧力調整弁付き、日本製電池セル、簡易防水など)
7. Made in Japan製品による確かな効き目(特許取得の国産ダイヤモンド電極をはじめ、電池セル、ポンプ、電子部品など細部まで国産品にこだわり製造)
■第1回感染対策EXPO大阪 出展のお知らせ
当社は、第1回感染対策EXPO大阪に出展参加し、会場にて実際にこのaqurayをお試しいただけます。
開催日時: 2021年2月24日(水)~26日(金) 10:00-17:00
会場 : インテックス大阪 4号館 ブース番号M2-2
URL : https://www.medical-jpn.jp/ja-jp/shows/ks.html
■オゾン水生成スプレーaquray(アクレイ)製品情報
品名 :aquray
型番 :HT2020-1
カラー:パールホワイト
価格 :オープン価格
品名 :aquray専用高純度精製水
型番 :HT2020-A
カラー:-
価格 :オープン価格
現在流行中の新型コロナウイルス(COVID-19ウイルス)をはじめ、2002年のSARS、2012年のMERSと、近年発生のウイルスや菌に対する危機管理のニーズが高まる中、当社は、安全と手軽さを両立できる除菌オゾン水生成スプレーを開発し、販売に至りました。
現在は、除菌・消臭などの衛生管理が必要とされる福祉施設、動物病院、ペットサロン、アミューズメント施設、教育施設、企業をはじめとする幅広い場所で使用されています。
当社のオゾン水生成スプレーaquray(アクレイ)は、ハンディータイプ・安価で、水だけで容易にオゾン水が生成できるため、大型・高額な従来のオゾン水生成機器と比べ、どこにでも手軽にオゾン水がスプレーでき、置き場所にも困りません。また、自社開発による国産ダイヤモンド電極を使用した電解式スプレー(特許出願中)により、確かな効き目のオゾン水を一定濃度で安定してスプレーできます。
噴射されたオゾン水は、対象物と反応すると消費され、すぐに水に戻る特性を有しており、薬剤や乾燥による手荒れのリスクが極めて低く、肌に非常にやさしく除菌することが可能です。
本製品は、除菌・消臭など衛生管理が必要とされる医療・介護施設、動物病院、ペットサロン、企業・工場、食品加工・飲食店、交通機関、アミューズメント施設、保育・教育施設、美容室・エステサロン、清掃、防災施設など様々な施設に向け、今後も幅広く販売する予定です。2021年度は約1万台を販売予定です。
■「aquray」本体の主な仕様
電源 :充電用電源アダプター
入力 :AC100-240V/50~60Hz
出力 :DC12V 1A
内蔵電池 :リチウムイオン電池
充電時間 :約3時間
使用温度範囲 :5~40℃
使用できる水の種類 :Type1:aquray専用高純度精製水
:Type2:市販の精製水、自社製造の精製水
:Type3:水道水(浄水器推奨)、市販ペットボトル飲料水
オゾン水濃度 :Type1:約2 ~ 3mg/L ※1
:Type2:約2 ~ 3mg/L ※1
:Type3:約1 ~ 2mg/L ※2
(いずれも水温25℃、直線スプレー時。※3)
噴霧量 :約70ml/min
カートリッジボトル容量:約270ml
防水 :簡易防水
外形寸法 :幅約98mm×奥行約116mm×高さ約254mm
ノズル :直線状/霧状 ノズル回転切替え式
重量 :約540g(水なし)
生産国 :日本※4
※1:導電率1μ S/cm 以下の精製水を用いてオゾン水を生成
※2:硬度約30mg/Lの水道水を用いてオゾン水を生成
上記※1※2はどちらも、紫外線吸光光度法により測定した値です。日本分光製分光光度計(V-730)使用。オゾン濃度測定方法(改訂版)(日本オゾン協会)引用
※3:オゾン水濃度は、使用する水質や水温、噴霧状態により変化します。
※4:オゾンウォータースプレー主要部品である電極、ポンプ、電池セル、主要回路基板部品、カートリッジボトルなどや、開発・設計・製造に関わる協力企業においても日本製・日本企業にこだわりaqurayを生産しています。
■伯東株式会社について
伯東株式会社は1953年の創業以来、電子部品から半導体製造装置までを取り扱うエレクトロニクス専門商社としての一面と、石油化学や製紙プラント、自動車業界向けに工業薬品を開発・製造するケミカルメーカーとしての一面を併せ持つ企業です。近年はこれまで培った技術を応用し、微生物産生多糖類の技術を用いた化粧品関連製品の展開など、新しい価値の創造に挑み続けています。企業活動を通じて「人と技術と自然環境の共存」できる未来を目指します。
払込資本金:81億円(2020年3月末現在)
従業員数 :連結 1,257名、単体 680名(2020年3月末現在)
年商 :連結 1,531億82百万円
単体 1,295億46百万円(2020年3月期)
<添付資料>
◎使用できる水 一覧表

オゾン水生成スプレーaquray(アクレイ)の原料として使用できる水一覧
※水道水の硬度は、お住まいの地域の水道局Web サイトなどをご参照ください。
※下記の水は、いずれのタイプを選択した場合でも、ご使用いただけません。
井戸水、炭酸水、フレーバーなど添加剤入り飲料水、経口補水液、バナジウム天然水、その他飲料水、雨水、温泉水、次亜塩素酸水、消毒用アルコール、エタノール、その他液体
■殺菌試験結果
【スプレー原料として精製水、水道水を使用した際の比較試験結果】
・黄色ブドウ球菌 in vitro殺菌試験 (菌接触時間30秒)
黄色ブドウ球菌(Staphylococcus aureus NBRC 12732)
→ 99.99%以上除菌効果確認
(JIS B 8701 次亜塩素酸水による殺菌効力測定試験方法における“殺菌性能”を有する)
黄色ブドウ球菌 in vitro殺菌試験結果(精製水、水道水使用比較)
試験事業者:日本微生物クリニック株式会社(JNLA登録試験事業者)
試験結果報告書日付、報告書No.:2020年3月20日、No.HKT200301AT-02
以降は、スプレーの原料としてaquray専用高純度精製水を使用した試験結果です。
第三者公的機関により、ウイルス、菌、酵母、カビに対するオゾン水の効果を試験し、確認済みです。
またオゾン水によるウイルスの不活化効果が論文などで発表されており、他社様の結果ではありますが、aqurayよりさらに低濃度(1mg/L未満)のオゾン水にて、新型コロナウイルスに対して不活化効果があることが既に報告されています。また、当社が所属する日本医療・環境オゾン学会においても、新型コロナウイルスに対するオゾン水の不活化効果を確認中です。
・ウイルス不活化試験
コロナウイルス(ネココロナウイルス)(Feline enteric coronavirus, WSU 79-1683)
(エンベロープウイルス)
→ 99.99%不活化効果確認
(新型コロナウイルスと同グループに属するコロナウイルスに対して高い不活化効果を確認済み)

コロナウイルス不活化効果
試験委託先 :日本微生物クリニック株式会社(JNLA登録試験事業者)
試験実施先(試験番号):一般財団法人北里環境科学センター 北環発2020_0079号
・エンベロープウイルスとノンエンベロープウイルスへの不活化試験比較

エンベロープウイルスとノンエンベロープウイルスへの不活化試験
→どちらも99.99%以上の不活化効果確認
(アルコールでは不活化が難しいノンエンベロープウイルスに対しても不活化効果確認)
試験委託先 :日本微生物クリニック株式会社(JNLA登録試験事業者)
試験実施先(試験番号):一般財団法人北里環境科学センター 北環発2020_0079号
※感染価:50%の細胞に対して感染するウイルス濃度
■安全性試験結果
OECD準拠 3次元培養皮膚・角膜モデル使用 化粧品安全試験

オゾン水噴霧による皮膚、眼粘膜に対する安全性試験結果
→ 高濃度オゾン水(濃度7mg/L)をスプレー後も、細胞生存率にはほぼ影響なく、無刺激性であることを確認済み
試験委託先 :株式会社マツモト交商
試験受託先 :DRC株式会社
試験結果報告書日付:2019年3月25日
試験結果報告書No. :皮膚一次刺激性試験190207-002
眼粘膜刺激性試験190207-003
■お客様からのお問い合わせ先
伯東株式会社 ケミカルソリューションカンパニー
営業企画部 事業開発グループ
〒160-8910 東京都新宿区新宿1-1-13
担当 : 阿野 哲也
電話 : 03-3225-8993
E-mail: ano-t@hakuto.co.jp















